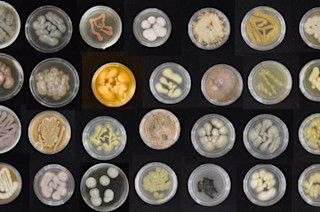

夏威夷拥有一些世界上最美丽的风景。迷人的蓝色海水、茂密的热带雨林和原始的海滩使其成为人间天堂。它也是其他独特居民的家园,例如海龟、海豚……以及塑料?
根据夏威夷大学马诺阿分校(UH)的一项新研究,塑料正成为海洋中最普遍的污染形式,这对海洋生物及其栖息地可能造成损害。然而,UH的研究人员在夏威夷近岸环境中发现了一种真菌,它可能具有分解塑料的能力,而且,经过驯化后,它们分解塑料的速度可能更快。这些研究结果最近发表在《Mycologia》杂志上。
“如今环境中的塑料寿命极长,并且几乎不可能通过现有技术进行降解,”该研究的首席作者、夏威夷大学马诺阿分校自然科学学院海洋生物学本科生Ronja Steinbach在一份新闻稿中说。
阅读更多: 微型机器人正在捕捞微塑料
意想不到的真菌
海洋真菌可能是一个你从未听说过的词。这很可能是因为目前已知的海洋真菌不到1%。
“我们的研究强调了海洋真菌是一个有前途且未被充分利用的群体,值得研究用于回收和清除自然界塑料的新方法。研究海洋真菌的人非常少,我们估计目前只有不到1%的海洋真菌被描述过,”Steinbach在新闻稿中说。
在这项研究中,研究团队考察了夏威夷近岸珊瑚、海藻、沙子和海绵中发现的海洋真菌。他们希望这些真菌能帮助降解海洋环境中的塑料。
“真菌拥有消化其他生物无法消化的东西(如木材或几丁质)的超能力,所以我们测试了我们收藏的真菌消化塑料的能力,”太平洋生物科学研究中心教授、该研究的联合首席作者Anthony Amend在新闻稿中说。
贪吃的真菌
研究小组将生长最快的真菌暴露在装有聚氨酯(一种常见塑料)的小培养皿中,并记录了真菌是否以及以多快的速度消耗它。研究小组还“通过实验进化”了这些真菌,以观察它们在暴露于塑料后是否会生长得更多、消耗得更快。
“令我们震惊的是,我们从海洋中收集的60%以上的真菌都具有某种程度的吞食塑料并将其转化为真菌的能力,”Steinbach在新闻稿中说。“我们也对真菌适应的速度印象深刻。非常令人兴奋的是,在短短三个月内,一些真菌的摄食率就提高了15%。”
研究团队目前正致力于研究这些海洋真菌是否能分解其他形式的塑料,例如聚乙烯和聚对苯二甲酸乙二醇酯。他们还在试图了解这些真菌在分子层面如何降解这些塑料。
“我们希望与工程师、化学家和海洋学家合作,他们可以将这些发现转化为实际解决方案,以清理我们的海滩和海洋,”Steinbach在新闻稿中说。
塑料问题
塑料的出现带来了巨大的消费模式改变。塑料不仅用途广泛,从容器到服装都有涉及,而且比以前使用的材料便宜得多。然而,塑料的缺点是它不易降解,并且可以存在数千年。
因此,各种形式的塑料都进入了水道,包括我们的海洋。虽然塑料不像其他材料那样分解,但它可以分解成称为微塑料的小颗粒,然后这些颗粒会进入我们的食物和饮用水供应。
此外,据研究人员称,这些塑料在暴露于阳光或强大外力(如海浪拍打)时,会释放出邻苯二甲酸酯和双酚A等有害化学物质,或者被海洋野生动物吞食,导致它们饥饿和死亡。塑料污染的影响并非仅限于夏威夷;它影响着所有海洋及其中的生命,以及依赖它们的人。
解决这个塑料问题不会一蹴而就。然而,UH研究团队认为,真菌可能是解决方案的一部分。
阅读更多: 我们的大脑吸收微塑料比其他器官更多
文章来源
我们的Discovermagazine.com作家在文章中采用同行评审研究和高质量来源,我们的编辑会审阅科学准确性和编辑标准。请查看本文使用的以下来源
《Mycologia》杂志。海洋真菌降解塑料,并可被驯化以加快速度
Ronja Steinbach,夏威夷大学马诺阿分校自然科学学院海洋生物学本科生
Anthony Amend,太平洋生物科学研究中心教授